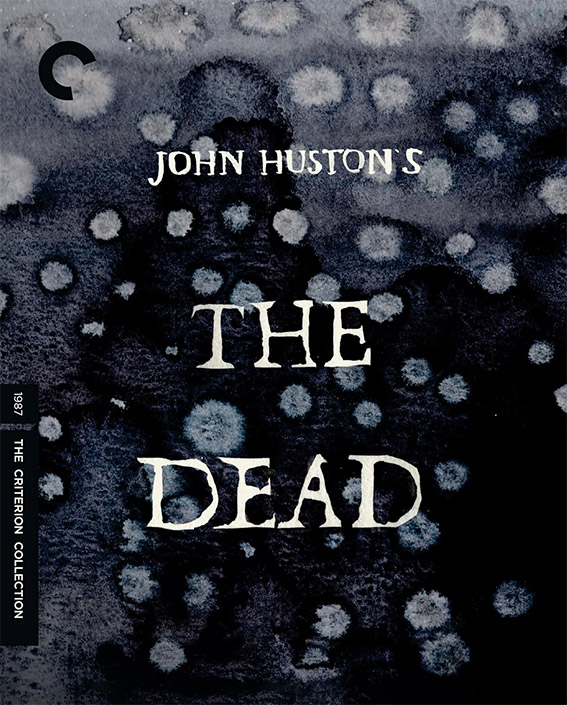
The Dead Criterion UHD cover

Dead Man, Yi Yi, The Dead and Captain Blood from Criterion UK in January
Spirit Entertainment has announced the Criterion UK release slate for January 2026, which will consist of Jim Jarmusch‘s first period piece, Dead Man, Edward Yang’s warm, sprawling and dazzling Yi yi, the elegiac last film by John Huston, The Dead, and the spectacular Errol Flynn romantic adventure, Captain Blood. Full details follow.

DEAD MAN (USA / Germany / Japan 1995)
4K UHD+Blu-ray | 12 January 2026
With Dead Man, his first period piece, Jim Jarmusch imagined the nineteenth-century American West as an existential wasteland, delivering a surreal reckoning with the ravages of industrialisation, the country’s legacy of violence and prejudice, and the natural cycle of life and death.
Accountant William Blake (Johnny Depp) has hardly arrived in the godforsaken outpost of Machine before he’s caught in the middle of a fatal lovers’ quarrel. Wounded and on the lam, Blake falls under the watch of the outcast Nobody (Gary Farmer), who guides his companion on a spiritual journey, teaching him to dispense poetic justice along the way.
Featuring austerely beautiful black-and-white photography by Robby Müller and a live-wire score by Neil Young, Dead Man is a profound and unique revision of the western genre.
DIRECTOR-APPROVED 4K UHD + BLU-RAY SPECIAL EDITION FEATURES:
- 4K digital restoration, supervised and approved by director Jim Jarmusch, with 2.0 surround DTS-HD Master Audio soundtrack
- One 4K UHD disc of the film and one Blu-ray with the film and special features
- Q&A in which Jarmusch responds to questions sent in by fans
- Footage of Neil Young composing and performing the film’s score
- Interview with actor Gary Farmer
- Readings of William Blake poems by members of the cast, including Mili Avital, Alfred Molina, and Iggy Pop, accompanied by Jarmusch’s location-scouting photos
- Selected-scene audio commentary by production designer Bob Ziembicki and sound mixer Drew Kunin
- Deleted scenes
- Trailer
- Color photos from the film’s production
- English subtitles for the deaf and hard of hearing
- PLUS: Essays by film critic Amy Taubin and music journalist Ben Ratliff
Cover by Nessim Higson

YI YI (Taiwan / Japan 2000)
4K UHD+Blu-ray | 19 January 2026
The extraordinary, internationally embraced Yi Yi, directed by the late Taiwanese master Edward Yang, follows a middle-class family in Taipei over the course of one year, beginning with a wedding and ending with a funeral.
Whether chronicling middle-aged father NJ’s tentative flirtations with an old flame or precocious young son Yang-Yang’s attempts at capturing reality with his beloved camera, the filmmaker deftly imbues every gorgeous frame with a compassionate clarity. Warm, sprawling, and dazzling, this intimate epic is one of the undisputed masterworks of the twenty-first century.
4K UHD + BLU-RAY SPECIAL EDITION FEATURES:
- New 4K digital restoration, with original theatrical 2.0 surround DTS-HD Master Audio soundtrack
- Alternate 5.0 surround DTS-HD Master Audio soundtrack
- One 4K UHD disc of the film and one Blu-ray with the film and special features
- Audio commentary featuring writer-director Edward Yang and Asian-cinema critic Tony Rayns
- Interview with Rayns about Yang and the New Taiwan Cinema movement
- U.S. theatrical trailer
- Original English subtitle translation by Yang and Rayns
- PLUS: An essay by critic Kent Jones and notes from the director
THE DEAD (Ireland / UK 1987)
4K UHD+Blu-ray | 26 January 2026
The elegiac last film by John Huston finds the legendary director adapting a masterly short story by his favourite writer, James Joyce, into a poignant reflection on the totality of life.
During a snowy winter in turn-of-the-twentieth-century Dublin, the members of an extended family convene for a night of wine, song, and celebration—but it’s not until after the festivities that Gretta (Anjelica Huston) reveals a secret to her husband (Donal McCann) that casts the entire evening in a new light.
Aglow with a mix of nostalgia and melancholy, and featuring a cast of stellar Irish actors, The Dead gracefully evokes the passage of time and the haunting power of memory.
4K UHD + BLU-RAY SPECIAL EDITION FEATURES:
- New 4K digital restoration, supervised and approved by director of photography Fred Murphy, with 4.0 surround DTS-HD Master Audio soundtrack
- One 4K UHD disc of the film presented in Dolby Vision HDR and one Blu-ray with the film and special features
- New interview with author Colum McCann on the James Joyce short story and its adaptation for the film
- New 2K restoration of John Huston and the Dubliners (1987), a behind-the-scenes documentary by Lilyan Sievernich
- Audio excerpts from actor Anjelica Huston’s 2014 memoir, Watch Me
- English subtitles for the deaf and hard of hearing
- PLUS: An essay by author and film critic Michael Koresky and a 1987 piece by screenwriter Tony Huston about the making of the film

CAPTAIN BLOOD (USA 1935)
4K UHD+Blu-ray | 26 January 2026
With this spectacular romantic adventure, a new era of Hollywood swashbuckling was born, as was a devilishly dashing star named Errol Flynn. He brings boundless charisma to the role of an idealistic Irish physician who, declared a traitor to England and sold into slavery in the New World, takes his revenge by transforming himself into the notorious pirate Captain Blood.
The groundbreaking symphonic score by Erich Wolfgang Korngold, marking the emergence of the Warner Bros. music department as a vital element in the studio’s moviemaking; the spitfire chemistry between Flynn and Olivia de Havilland in the first of their iconic pairings; the rousing naval-battle finale—all come together under the expert direction of Michael Curtiz to form an exemplar of classic film craftsmanship sailing full speed ahead.
4K UHD + BLU-RAY SPECIAL EDITION FEATURES:
- New 4K digital restoration, with uncompressed monaural soundtrack
- One 4K UHD disc of the film and one Blu-ray with the film and special features
- Audio commentary featuring Alan K. Rode, author of Michael Curtiz: A Life in Film
- Documentary from 2005 on the making of the film
- Lux Radio Theatre adaptation of the film from 1937, starring Errol Flynn, Olivia de Havilland, and Basil Rathbone
- Trailer
- English subtitles for the deaf and hard of hearing
- PLUS: An essay by critic Farran Smith Nehme
